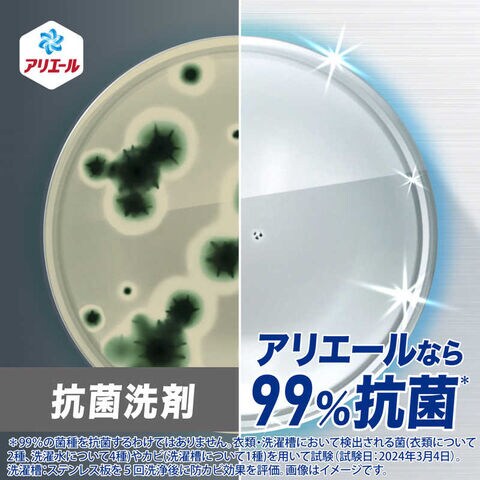

2/6
時点_ポイント最大11倍
P&G (ケース販売) アリエール ジェル 部屋干しプラス つめかえ 超ウルトラジャンボサイズ 1720g×4個
発売日:2025/03/22
販売価格
6,260
円 (税込)
送料無料
- 出荷目安:
- 『お届け目安』をご確認の上ご注文ください
たまるdポイント(通常) 56
+キャンペーンポイント(期間・用途限定) 最大10倍
※たまるdポイントはポイント支払を除く商品代金(税抜)の1%です。
※表示倍率は各キャンペーンの適用条件を全て満たした場合の最大倍率です。
各キャンペーンの適用状況によっては、ポイントの進呈数・付与倍率が最大倍率より少なくなる場合がございます。
dカードでお支払ならポイント3倍
各キャンペーンの適用状況によっては、ポイントの進呈数・付与倍率が最大倍率より少なくなる場合がございます。
- 商品情報
- レビュー
当店をご利用の前にご確認ください
コジマのトップページはこちら
【商品解説】
NEW 部屋まで!まるごと消臭!*1最高レベルの抗菌成分*2 18時間抗菌*3干した衣服も部屋もW消臭!*1 厚手タオルやパーカーの生乾き臭も徹底消臭*1 洗濯サイクルエンドレス消臭!脱ぐ瞬間までニオイ断つ!*1洗濯槽の防カビ*410%濃縮!*5 少ない量で同じだけ洗える縦型・ドラム式・すすぎ1回OK*1 P&G調べ。
ニオイの度合いで消臭の程度は異なります。
*2 アリエール超抗菌プレミアムシリーズにおいて。
*3 全ての菌の増殖を抑えるわけではありません。
*4 カビは除去しません。
*5 2023年のアリエール超抗菌プレミアムシリーズ比。
洗濯洗剤
【スペック】
●型式:(アリエルヘヤSUJケス)
●JANコード:4987176309204
【注意事項・特記事項】
※キャンペーンやパッケージリニューアル等で掲載画像とは異なる場合があります。
※開封後の返品や商品交換はお受けできません。
配送区分:宅配便
この商品は、宅配便でお届けする商品です。
配送エリアの確認はこちら
お買い上げ合計3,000円以上で送料無料となります。
※3,000円未満の場合は、一律550円(税込)となります。
●出荷可能日から最短日時でお届けします。(日時指定は出来ません。)
※お届け時に不在だった場合は、「ご不在連絡表」が投函されます。
「ご不在連絡表」に記載された宅配業者の連絡先へ、再配達のご依頼をお願い致します。
●お届けは玄関先までとなります。
●宅配便でお届けする商品をご購入の場合、不用品リサイクル回収はお受けしておりません。
●全て揃い次第の出荷となりますので、2種類以上、または2個以上でのご注文の場合、出荷が遅れる場合があります。
コジマのトップページはこちら
【商品解説】
NEW 部屋まで!まるごと消臭!*1最高レベルの抗菌成分*2 18時間抗菌*3干した衣服も部屋もW消臭!*1 厚手タオルやパーカーの生乾き臭も徹底消臭*1 洗濯サイクルエンドレス消臭!脱ぐ瞬間までニオイ断つ!*1洗濯槽の防カビ*410%濃縮!*5 少ない量で同じだけ洗える縦型・ドラム式・すすぎ1回OK*1 P&G調べ。
ニオイの度合いで消臭の程度は異なります。
*2 アリエール超抗菌プレミアムシリーズにおいて。
*3 全ての菌の増殖を抑えるわけではありません。
*4 カビは除去しません。
*5 2023年のアリエール超抗菌プレミアムシリーズ比。
洗濯洗剤
【スペック】
●型式:(アリエルヘヤSUJケス)
●JANコード:4987176309204
【注意事項・特記事項】
※キャンペーンやパッケージリニューアル等で掲載画像とは異なる場合があります。
※開封後の返品や商品交換はお受けできません。
配送区分:宅配便
この商品は、宅配便でお届けする商品です。
配送エリアの確認はこちら
お買い上げ合計3,000円以上で送料無料となります。
※3,000円未満の場合は、一律550円(税込)となります。
●出荷可能日から最短日時でお届けします。(日時指定は出来ません。)
※お届け時に不在だった場合は、「ご不在連絡表」が投函されます。
「ご不在連絡表」に記載された宅配業者の連絡先へ、再配達のご依頼をお願い致します。
●お届けは玄関先までとなります。
●宅配便でお届けする商品をご購入の場合、不用品リサイクル回収はお受けしておりません。
●全て揃い次第の出荷となりますので、2種類以上、または2個以上でのご注文の場合、出荷が遅れる場合があります。